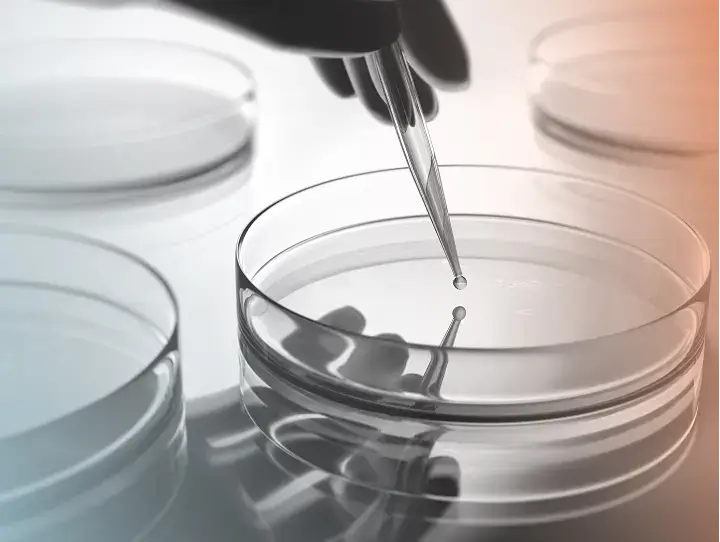

Discover HLA-Compass
Web-accessible HLA peptide database
Alithea’s web-accessible HLA peptide database HLA Compass comprises 1.4 million unique peptides and 10,000 cancer specific epitopes deriving from >17 million identifications in 4,160 high-quality HLA peptidomics samples, meticulously collected from healthy organs, cancer cell lines, and tumor tissues. Each peptide in this extensive database is grounded in real-world biological data, reflecting the actual peptide presentation on HLA complexes in these diverse tissue types.
Get the HLA-CompassUnique benefits of HLA-Compass
Unified bioinformatics pipeline based on Alithea’s deep domain knowledge and bioinformatic tools
All peptides are linked to quantitative information allowing for relative quantification between thousands of samples
Intuitive user interface allows for easy browsing of peptide and protein data
Tools to identify off-targets from lists of potential candidates or similarity searching (e.g. with x-scan data)
All peptides are mapped to cognate HLA alleles through Alithea’s proprietary HLA binding predictors
Stringent quality control based on Alithea’s deep domain knowledge and bioinformatic tools
The numbers behind HLA-compass
Alithea’s web-accessible HLA peptide database HLA Compass comprises 1.4 million unique peptides and 10,000 cancer specific epitopes deriving from >17 million identifications in 4,160 high-quality HLA peptidomics samples, meticulously collected from healthy organs, cancer cell lines, and tumor tissues.
Each peptide in this extensive database is grounded in real-world biological data, reflecting the actual peptide presentation on HLA complexes in these diverse tissue types.
Contact us for more details
HLA Compass access options on “per-request” basis:
- interrogating presentation of single peptides via peptide-centric analysis
- interrogating presentation of all peptides from certain genes via gene-centric analysis
- getting evidence for the presentation of putative off-targets y submitting lists of peptides for off-target analysis
- identifying potential off-targets through off-target analysis (link) based on Alanine or x-scan data
- re-searching subsets of the data for evidence that putative n
HLA-Compass
AI that understands immunopeptidomics.
Ask a question. The copilot queries proprietary HLA data, picks the right MCP tool, and runs a governed analysis — so you can discover neoantigens in minutes, not months.
How it works
From question to governed answer in three steps
Ask in natural language
Describe your research question — the copilot understands immunopeptidomics terminology, your data context, and available tools.
AI selects and chains tools
The copilot reads MCP descriptors from the tool marketplace, selects the right analytical module, configures inputs, and plans the execution.
Governed execution with audit trail
Every action is logged, budget-controlled, and traceable. You get results with full provenance — which data, which tool, which model.
AI Copilot Playground
Ask a question. Get a governed answer.
Interact with our autonomous immunopeptidomics assistant. Select a prompt preset below, or type a custom question to see how the AI Copilot maps datasets and executes governed MCP tools in real-time.
I will query the local ligandome database for KRAS G12D neoepitopes restricted to HLA-A*02:01, then filter against your active lung tissue cohorts.
Found 3 peptides from KRAS G12D on HLA-A*02:01 in lung_tissue_batch_04. Two pass the presentation threshold with high confidence (q-value < 0.01).
How HLA-Compass compares with alternatives
Different approaches win for different jobs. Public atlases are better for open, citable reference checks, prediction tools are faster for sequence ranking, specialist services are stronger for bespoke wet-lab programs, and in-house stacks maximize control at the cost of time.
| HLA-Compass | Public atlasesHLA Ligand Atlas / SysteMHC Atlas | Prediction toolsNetMHCpan / MHCflurry | Specialist servicesPure MHC / CRO workflows | In-house stack | |
|---|---|---|---|---|---|
| Experimentally observed HLA peptides | If instrumented | ||||
| Open/public reference access | |||||
| Private workspace for proprietary programs | Project-based | ||||
| Healthy tissue context for off-target review | Partial | Partial | Partial | ||
| Self-serve interactive usage | Partial | ||||
| Governed execution / audit layer | Possible | ||||
| Custom workflow control | Partial | Partial | |||
| Time to first result | Immediate | Immediate | Immediate | Weeks | Months |